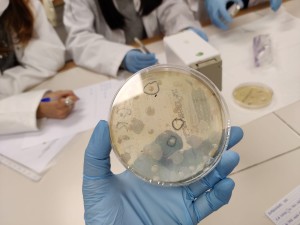
IMG-20210310-WA0003

Sembra de bacteris al laboratori
Els alumnes de Biologia han realitzat una interessant pràctica de laboratori. Han sembrat bacteris de la boca i els han posat en discos impregnats en diferents col·lutoris, per tal de veure l’halo de cadascun, és a dir, el cercle al voltant del disc on no hi ha creixement microbià. A les fotos podeu veure tant el resultat de l’experiment com els alumnes en acció.